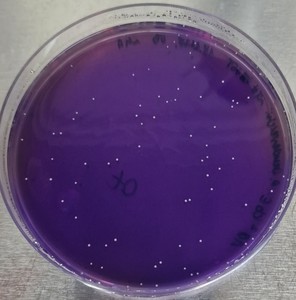
Propionibacterium freudenreichii-Kolonien auf einer selektiven Lithium-Glycerol Agarplatte

Projekt des Monats März 2026
Natürlich angereichert statt supplementiert: Fermentation als Schlüssel für Vitamin B12 in pflanzlichen Alternativen zu Fleisch- und Milchprodukten

© Soramony Sam | Uni Hohenheim
Das pflanzliche Fettgel besteht aus einer Emulsion mit 70 % Fettanteil.
Pflanzliche Alternativen zu Fleisch- und Milchprodukten haben sich vom Nischenprodukt zu einem festen Bestandteil moderner Ernährung entwickelt. Mit der zunehmenden Etablierung pflanzlicher Alternativen in der Ernährung gewinnen jedoch auch ernährungsphysiologische Fragestellungen an Bedeutung – so auch die bedarfsgerechte Versorgung mit Vitamin B12. Da dieses essenzielle Vitamin natürlicherweise fast ausschließlich in tierischen Lebensmitteln vorkommt, können Menschen, die sich vegan ernähren, ihren Bedarf nur über Nahrungsergänzungsmittel oder angereicherte Lebensmittel decken. Für bestimmte Zielgruppen, etwa Menschen mit eingeschränkter Vitamin-B12-Resorption infolge der Einnahme von Protonenpumpenhemmern, ist die Sicherstellung einer bedarfsgerechten Versorgung ebenfalls erschwert.

© Soramony Sam | Uni Hohenheim
Die Emulsion mit 70 % Fettanteil wird durch Pflanzenproteine (z. B. Soja oder Erbse) stabilisiert und durch Erhitzen mit Transglutaminase vernetzt und gefestigt, wodurch man ein schnittfestes Gel erhält.
An genau diesem Punkt setzt ein transnationales Projekt der Industriellen Gemeinschaftsforschung (IGF) an, das vom FEI im Rahmen von CORNET (Collective Research Networking) koordiniert wird: Forschungsteams der Universität Hohenheim (
Institut für Lebensmittelwissenschaft und Biotechnologie, FG Lebensmittelmaterialwissenschaften |
Institut für Lebensmittelwissenschaft und Biotechnologie, FG Lebensmittelmikrobiologie und -hygiene) und der KU Leuven arbeiten gemeinsam daran, fermentierte pflanzliche Wurst- und Käseanaloga zu entwickeln, die nicht nur sensorisch überzeugen, sondern zugleich ein verbessertes Nährstoffprofil aufweisen – insbesondere durch eine natürliche Anreicherung mit bioverfügbarem Vitamin B12.

© Soramony Sam | Uni Hohenheim
Texturierte Pflanzenproteine und ein pflanzliches Fettgel bilden die Grundmasse der veganen Salamimatrix, welche durch ein Bindesystem von Pektin und Weizengluten zusammengehalten wird.
Durch die internationale Zusammenarbeit werden komplementäre Kompetenzen aus Lebensmittelmaterialwissenschaft, Mikrobiologie und Prozesstechnologie gebündelt, um praxisnahe Lösungen für die industrielle Anwendung zu erarbeiten.
Im Mittelpunkt der Arbeiten steht unter anderem
Propionibacterium freudenreichii, ein Mikroorganismus, der Vitamin B12 in relevanten Mengen und in einer für den Menschen gut resorbierbaren Form bilden kann.
© Elena Bauersachs | Uni Hohenheim
Propionibacterium freudenreichii-Kolonien auf einer selektiven Lithium-Glycerol Agarplatte
Die zentrale Herausforderung besteht darin, Fermentationsbedingungen so zu steuern, dass eine zuverlässige Vitamin-B12-Produktion mit den gewünschten sensorischen und technologischen Produkteigenschaften vereinbar ist. Dabei spielen sowohl die Zusammensetzung der pflanzlichen Matrix – etwa auf Basis von Erbsen-, Soja- oder Rapsproteinen – als auch die Auswahl geeigneter Co-Kulturen eine entscheidende Rolle. Untersucht wird daher, wie sich unterschiedliche Starterkulturen, Prozessparameter und Rezepturen gegenseitig beeinflussen.

© Soramony Sam | Uni Hohenheim
Vegane Snack-Salami vor der Trocknung.

© Soramony Sam | Uni Hohenheim
Salamis nach dem Trocknungsprozess.
Erste Erkenntnisse aus Vorarbeiten zeigen, dass insbesondere die Co-Kultivierung mit Milchsäurebakterien nicht nur für Säuerung und Aromabildung relevant ist, sondern auch die Vitamin-B12-Synthese positiv beeinflussen kann. Neben der reinen Vitaminmenge wird konsequent auch die Bioverfügbarkeit des gebildeten Vitamins analysiert, um eine tatsächliche ernährungsphysiologische Wirksamkeit sicherzustellen. Das Vorhaben baut auf zwei erfolgreich abgeschlossenen Projekten auf (dem IGF-Projekt
01IF21931N und dem CORNET-Projekt
01IF00364C), in denen bereits umfangreiche Erkenntnisse zur Fermentation pflanzlicher Rohstoffe sowie zur mikrobiellen Struktur- und Prozesssteuerung gewonnen wurden.

© Soramony Sam | Uni Hohenheim
Am Ende des Prozesses erhält man die schnittfeste vegane Salami.
Aus wirtschaftlicher Sicht adressiert das Projekt eine Branche mit hohem Wachstumspotenzial: Der europäische Markt für pflanzliche Lebensmittel verzeichnet seit Jahren zweistellige Zuwachsraten, insbesondere bei Fleisch- und Milchalternativen. Das Projekt richtet sich daher gezielt an kleine und mittlere Unternehmen sowie größere Hersteller entlang der Wertschöpfungskette – von Produzenten pflanzlicher Proteine über Starterkulturhersteller bis hin zu Verarbeitungsbetrieben.
Durch den Zugang zu wissenschaftlich fundierten Fermentationsstrategien können Unternehmen innovative Produkte mit klarem Mehrwert entwickeln. Langfristig trägt VegVit dazu bei, pflanzliche Alternativprodukte nicht nur nachhaltiger, sondern auch ernährungsphysiologisch hochwertiger zu gestalten. Damit leistet das Projekt einen wichtigen Beitrag zur Weiterentwicklung fermentierter pflanzlicher Lebensmittel und stärkt zugleich die Wettbewerbsfähigkeit in einem dynamisch wachsenden Markt.
Informationen zum IGF-Projekt 01IF00424C
"Lösungsansätze zur Verbesserung des Vitamin-B12-Problems bei pflanzlichen Alternativen durch Fermentation"
... ein Projekt der Industriellen Gemeinschaftsforschung (IGF)